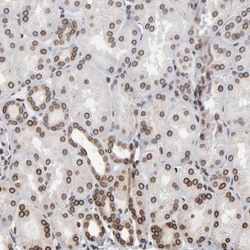
Nesprin 2 Antibody, Novus Biologicals:Antibodies:Primary Antibodies

missing translation for 'onlineSavingsMsg'
Learn More
Learn More
Nesprin 2 Antibody, Novus Biologicals™
Rabbit Polyclonal Antibody has been used in 2 publications
216.00 € - 539.00 €
Specifications
| Antigen | Nesprin 2 |
|---|---|
| Concentration | 0.3mg/mL |
| Dilution | Western Blot Reported in scientific literature (PMID: 31006653)., Immunohistochemistry 1:200 - 1:500, Immunohistochemistry-Paraffin 1:200 - 1:500 |
| Applications | Western Blot, Immunohistochemistry, Immunohistochemistry (Paraffin) |
| Classification | Polyclonal |
| Product Code | Brand | Quantity | Price | Quantity & Availability | |||||
|---|---|---|---|---|---|---|---|---|---|
| Product Code | Brand | Quantity | Price | Quantity & Availability | |||||
|
18406240
|
Novus Biologicals
NBP1-84190-25ul |
25 μL |
216.00 €
25µL |
Please sign in to purchase this item. Need a web account? Register with us today! | |||||
|
18758373
|
Novus Biologicals
NBP1-84190 |
0.1 mL |
539.00 €
0.10mL |
Please sign in to purchase this item. Need a web account? Register with us today! | |||||
Description
Nesprin 2 Polyclonal specifically detects Nesprin 2 in Human, Rat samples. It is validated for Western Blot, Immunohistochemistry, Immunohistochemistry-Paraffin.Specifications
| Nesprin 2 | |
| Western Blot Reported in scientific literature (PMID: 31006653)., Immunohistochemistry 1:200 - 1:500, Immunohistochemistry-Paraffin 1:200 - 1:500 | |
| Polyclonal | |
| Rabbit | |
| Developmental Biology | |
| PBS (pH 7.2) and 40% Glycerol with 0.02% Sodium Azide | |
| DKFZP434H2235, DKFZp686E01115, DKFZp686H1931, EDMD5, FLJ46790, KIAA1011FLJ11014, nesprin 2, nesprin-2, NUAFLJ43727, NUANCEFLJ45710, Nuclear envelope spectrin repeat protein 2, Nucleus and actin connecting element protein, polytrophin, Protein NUANCE, spectrin repeat containing, nuclear envelope 2, Synaptic nuclear envelope protein 2, synaptic nuclei expressed gene 2, SYNE-2, TROPH | |
| SYNE2 | |
| IgG | |
| Affinity Purified | |
| Specificity of antibody verified on a Protein Array containing target protein plus 383 other non-specific proteins. |
| 0.3mg/mL | |
| Western Blot, Immunohistochemistry, Immunohistochemistry (Paraffin) | |
| Unconjugated | |
| RUO | |
| Human, Rat | |
| Q8WXH0 | |
| 23224 | |
| This antibody was developed against Recombinant Protein corresponding to amino acids:NVLNDAYENLTRYKEAVTRAVESITSLEAIIIPYRVDVGNPEESLEMPLRKQEELESTVARIQDLTEKLGMISSPEAKLQLQYTLQELVSKNSAMKEAFKAQETEAE | |
| Primary | |
| Store at 4C short term. Aliquot and store at -20C long term. Avoid freeze-thaw cycles. |
For Research Use Only
Spot an opportunity for improvement?Share a Content Correction
Product Content Correction
Your input is important to us. Please complete this form to provide feedback related to the content on this product.
Product Title